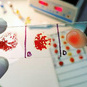
course-image-6685.jpg

Welcome to our eLearning store developed by experienced transfusion medicine professionals. Choose the course that is best suited for your transfusion training and begin to sharpen your transfusion knowledge.
Become a member and get your class for free! If you are a member already, make sure you are logged in and go to My Account - My courses.
You can follow all our courses at your own pace from the comfort of your own home. Classes take one to two hours to complete on average. They can be completed in one or multiple sessions - whatever you prefer.
Start sharpening your knowledge of transfusion medicine today!
The courses about Transfusion Reactions (in English, Spanish, French and Portuguese) and the case study on Rare blood is available free of charge via My Account - My courses. You will only be asked to register so that your progress is saved and you will be able to continue where you left off when you login again.